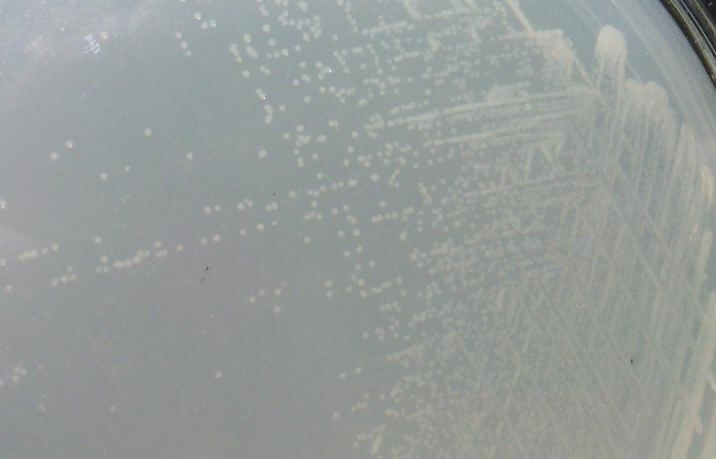
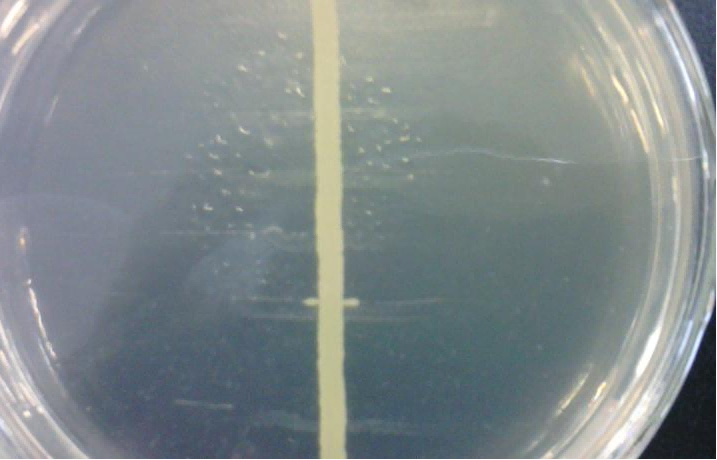

副猪格拉菌(Glaesserella parasuis,Gps)原名副猪嗜血杆菌(Haemopilus parasuis,Hps),是一种革兰阴性短小杆菌,临床上常致保育仔猪患关节炎、脑膜炎、多发性纤维素性浆膜炎等副猪格拉菌病,又称猪格氏病(Glaesser's disease)。Gps是猪上呼吸道常在细菌,健康猪只身上也会携带,属于条件致病菌,在猪只免疫力下降、转圈、运输、温度变化等刺激条件下极易发病。该病是生猪养殖业中较为常见的细菌性传染病,传播快,尤其对保育仔猪的影响最为严重,致死率较高,即使耐过,也会成为僵猪,干吃不长肉,给养猪产业带来重大经济损失。有效地鉴别、治疗、防控该病,对生猪养殖业具有非常重要的意义。本文通过对武平县某猪场暴发的仔猪副猪格拉菌病的诊断、治疗、防控等进行阐述,为生猪养殖业提供临床参考。
1、发病背景
武平县武东镇某猪场2025年8月1日从周宁县购买50日龄仔猪500头,隔离饲养约10 d后部分仔猪出现高热、被毛粗糙凌乱、食欲减退、精神萎靡,发病后期出现扎堆、弓背、跛行、呼吸困难等症状,先后病死6头仔猪。8月20日该猪场向笔者单位报告,寻求帮助。
2、诊治情况
2.1临床症状
发病猪只精神不振、形体消瘦、被毛粗糙凌乱、不同程度高热(见图1),发病较重的仔猪可见关节肿大、走路跛行或打拐、波浪式腹式呼吸、腹部膨大。经了解,该猪场未进行副猪格拉菌疫苗免疫。
1、发病背景
武平县武东镇某猪场2025年8月1日从周宁县购买50日龄仔猪500头,隔离饲养约10 d后部分仔猪出现高热、被毛粗糙凌乱、食欲减退、精神萎靡,发病后期出现扎堆、弓背、跛行、呼吸困难等症状,先后病死6头仔猪。8月20日该猪场向笔者单位报告,寻求帮助。
2、诊治情况
2.1临床症状
发病猪只精神不振、形体消瘦、被毛粗糙凌乱、不同程度高热(见图1),发病较重的仔猪可见关节肿大、走路跛行或打拐、波浪式腹式呼吸、腹部膨大。经了解,该猪场未进行副猪格拉菌疫苗免疫。

图1患病猪图片
2.2病理解剖
将报备当日死亡的两头仔猪和发病症状严重的一头仔猪进行解剖,解剖可见肿大关节腔中有清亮半透明积液(见图2-A),腹腔(见图2-B)和心包(见图2-C)有黄色半透明积液,脾脏肿大(见图2-D),腹股沟(见图2-E)和肠系膜淋巴结(见图2-F)肿大。

图2病理解剖图片
2.3实验室检测
采集病死猪的心脏、关节腔积液和腹腔积液进行细菌的分离培养和“卫星现象”鉴定检测。
2.3.1 Gps的分离培养
在无菌操作条件下从病料中取样接种于TSA(胰酪大豆胨琼脂)培养基,置于37℃恒温培养箱中培养24 h后,TSA平板上长出灰白透明0.3~0.5 mm大小的圆润光滑菌落(见图3)。
图3 Gps在TSA培养基上生长形态
从TSA培养皿中挑取疑似Gps菌落涂片进行革兰氏染色镜检,光学显微镜(×1 000)下观察,可见长度不等的革兰氏阴性小杆菌和球杆菌,无鞭毛和芽孢(见图4)。

图4 Gps革兰氏染色镜检图片
2.3.2“卫星现象”鉴定
挑取疑似Gps菌落,在未添加NAD(烟酰胺腺嘌呤二核苷酸)的TSA平板上水平划线接种,再挑取金黄色葡萄球菌垂直于Gps水平线划线,37℃恒温培养48 h后,TSA平板上出现明显的“卫星现象”(见图5)。
图5 Gps在金黄色葡萄球菌两侧形成“卫星现象”
2.4诊断结果
根据临床症状、病理解剖和实验室检测,可以确诊为仔猪副猪格拉菌病。
2.5治疗方案
采用敏感抗生素药物治疗+全面消毒的综合防治方案。
2.5.1药物治疗
确诊后,选用对Gps敏感的抗生素进行治疗,发病栏猪在颈部三角肌处按药品说明书一侧注射恩诺沙星和头孢噻呋钠,另一侧注射安痛定。同时进行群体防治,在同批次仔猪饲料中添加阿莫西林和磺胺氯哒嗪钠粉剂。持续治疗14 d。
2.5.2全面消毒
患病严重的仔猪已经失去治疗价值,将患病严重的猪和病死猪进行无害化处理,患猪与健康猪分开饲养。对猪舍进行全面彻底消毒,先将猪舍内的粪便、污水、饲料残渣、器具等清理出去,对猪舍地面、墙壁、栏杆等地方进行全面冲洗,再用0.2%次氯酸钠消毒液全面喷洒,2次/d。为防止产生耐药性,5 d后更换消毒液,用0.1%新苯扎氯铵带猪喷雾消毒,2次/d,连续消毒10 d。
2.6治疗效果
经综合治疗,5 d后猪群的整体精神状况好转、食欲饮欲增加、体温正常,关节炎症状得到改善,无新增重症病例和死亡猪,连续用药14 d后,猪群全部康复。
3、分析与讨论
3.1准确进行鉴别诊断,最大限度降低经济损失
Gps病与链球菌病都会引起猪关节炎,病理变化方面有相似之处,在进行Gps病的诊断时要准确鉴别,选取对应的敏感抗生素才能有效治疗。Gps会引起波浪式腹式呼吸,链球菌病一般不会有呼吸道症状。Gps引起的是浆液性炎症,通常只表现为关节处肿大,刺破或切开可见关节腔内有淡黄色清亮积液,链球菌引起的是弥漫性的化脓性炎症,会从关节处不断向前后蔓延,导致整条腿肿大,刺破或切开可见关节腔内有灰白色脓性积液。考虑到生产实际,实验室检测会增加生产成本和时间成本,准确把握不同疾病相似症状之间的鉴别诊断可及时进行有效治疗,最大限度降低养殖场的损失。
3.2准确选取敏感抗生素,才能有效治疗Gps病
不同地区的Gps耐药性存在差异,猪场的用药习惯也会影响Gps的耐药性,根据邱建龙的研究,福建地区的Gps对阿奇霉素、氨苄西林、头孢噻肟和氯霉素等较为敏感,对四环素耐药率较高,而浙江某猪场生产中常用抗菌药为β-内酰胺类和磺胺类,从该猪场分离到的Gps对氨苄西林等β-内酰胺类抗菌药具有明显耐药性。因此在治疗副猪格拉菌病时要结合地方流行菌株和猪场用药习惯,选取敏感抗生素进行治疗。有条件的猪场可以进行Gps的血清型鉴定和药敏试验,根据试验结果选取敏感型抗菌药。
3.3做好科学疫苗接种,有效预防产生耐药菌株
目前抗生素的使用仍然是预防和治疗副猪格拉菌病的重要方式,随着抗生素的单一用药和滥用,全国各地Gps对许多抗生素都出现了不同程度的耐药性,接种Gps疫苗是减少使用抗生素预防产生耐药菌株的有效方式。
Gps的血清型较多,主要分为1~15型和不可分型菌株,各血清型毒力、致病性和地理分布都有显著差异,且各血清型之间的交叉免疫保护较低。通过疫苗免疫预防Gps病,最好经实验室检测确定Gps的血清型,有针对性的选择疫苗。Gps在中国地区的主要流行血清型为4、5、12、13型,没有条件做Gps血清型鉴定的猪场可以选择由以上几个血清型制成的四价联合疫苗,并按说明书接种疫苗。
Gps病常作为猪圆环病毒病和猪蓝耳病等免疫抑制性疾病的继发病,猪圆环病毒病和猪蓝耳病的控制也至关重要,仔猪可以在14日龄时接种猪圆环病毒疫苗,在20日龄接种猪蓝耳病疫苗。
4结束语
综上所述,Gps病是生猪产业常发细菌性传染疾病,既是原发病也是免疫抑制性疾病的继发病,对保育仔猪的危害较大。早发现早治疗,采用敏感性抗生素治疗疗效显著,科学制定疫苗免疫接种是预防产生耐药菌株的有效方式。
















